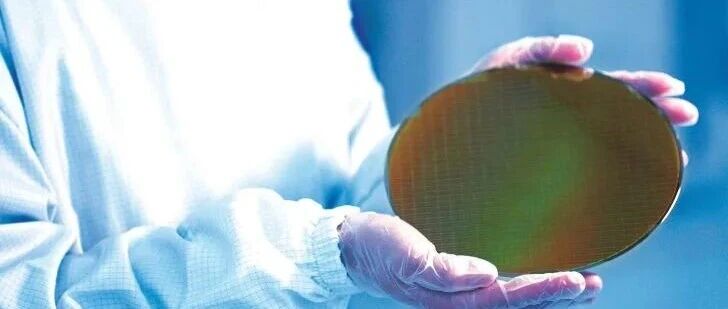

据报道,三星2纳米GAA工艺良率提升至50%,已向代工合作伙伴下发指南,开始推广全新升级的SF2P技术。
最新报告称,三星公司的2纳米GAA(全环绕栅极)工艺良率已达到50%,Exynos 2600芯片的表现证明了三星在下一代制程节点上取得了可观的进展。在这家韩国代工巨头试图进一步提高上述良率数据的同时,该公司也已向客户发送指南,开始推广SF2P节点(即第二代2纳米GAA节点),该节点相比前代产品进行了多项改进。
三星已向设计解决方案合作伙伴(DSP)发送指令,要求优先推广其第二代2纳米GAA工艺,而非第一代迭代版本。此前有消息称,三星于2025年9月开始量产Exynos 2600时,其2纳米GAA工艺的良率估计为50%,目标设定为70%。根据最新信息,三星的良率目前没有任何提升,但相比其3纳米GAA技术仍有大幅增长——三星3纳米工艺的良率当时未能突破30%的门槛,这曾导致该公司难以争取到客户。
预计第一代2纳米GAA工艺的良率会有小幅提升,但报告也指出,三星正将重心转移至第二代迭代版本。此前,三星已完成SF2P节点的基本设计,其第三代2纳米GAA工艺(又称SF2P+)预计将在两年内投入使用。
一位了解三星计划业内人士表示,三星目前正致力于开发SF2P技术,其基本工艺设计套件(PDK)已于去年年中完成。预计明年推出的Exynos 2700将采用该技术,据悉该芯片将支持LPDDR6内存和UFS 5.0存储等更新标准。
除了三星即将推出的旗舰级SoC外,特斯拉的AI6芯片也将在SF2P节点上量产,此前双方曾签署了一项价值165亿美元的巨额协议。此外,两家加密货币矿机制造商——比特微(MicroBT)和嘉楠科技(Canaan)——已向三星下达了2纳米GAA芯片订单,这突显了该公司在短短12个月内取得的进展。
不过,三星要成为台积电(TSMC)的威胁仍需数年时间,但该公司已设定了到2027年实现盈利的目标,为未来奠定了坚实的基础。
三星计划于年内关停一座8英寸晶圆代工产线,将重心转向利润更为丰厚、用于生产先进芯片的12英寸晶圆代工产线。
消息人士透露,三星将于今年下半年关停其位于器兴园区的一座名为 S7 的8英寸晶圆厂。该园区共运营三座8英寸晶圆厂,分别为 S6、S7 和 S8。其中 S6 与 S8 将继续维持运营。关停 S7 产线意味着,三星8英寸晶圆的月产能将从 25 万片降至 20 万片以下。据悉,S7 的月产能为 5 万片。目前,该产线的客户订单已开始向其他晶圆厂转移。三星对于 S7 关停后所闲置的厂房空间如何规划,目前尚不明确。
消息人士表示,三星旗下8英寸晶圆厂当前的开工率约为 70%。三星目前已将 CMOS 图像传感器、显示驱动芯片等主力产品的生产重心,大多转移至 12 英寸晶圆厂。这直接导致8英寸晶圆厂的开工率下滑。三星的研发人员也将精力集中在 12 英寸晶圆厂的相关业务上,继续维持8英寸晶圆厂的运营成本正日益高昂。
消息人士称,三星晶圆代工部门的客户数量少于竞争对手,量产芯片的品类也相对有限。因此,在开工率偏低的情况下,公司很可能判定无需继续维持三座8英寸晶圆厂的运营。
本文转自媒体报道或网络平台,系作者个人立场或观点。我方转载仅为分享,不代表我方赞成或认同。若来源标注错误或侵犯了您的合法权益,请及时联系客服,我们作为中立的平台服务者将及时更正、删除或依法处理。
